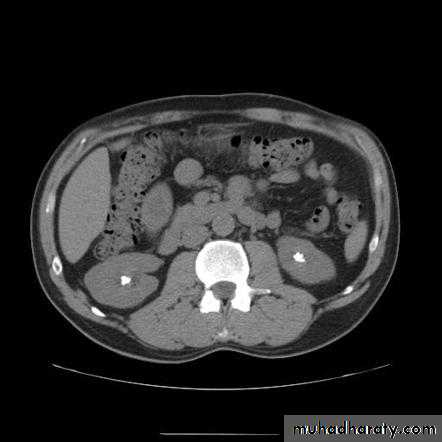

Urinary system imaging
ByDr. Firas Abdullah
Aims of our lecture:
To know the different radiological techniques used in urinary tractTo know different renal pathologies.
Urinary bladder diseases
Prostate and urethra disease
Scrotal and testicular disorders
Female genital organs imaging
I) Radiological techniques used in urinary tract imaging:
UltrasonographyUrography
CT scan
MRI
Radionuclide scanning
Special techniques:
Retrograde and antegrade pyelography
Voiding cystourethrogram (micturating cystogram) and videourodynamics
Urethrography
Renal arteriography.
Ultrasonography:
Investigate patients with symptoms thought to arise from the urinary tract.
Demonstrate the size of the kidneys and exclude hydronephrosis in patients with renal failure.
Diagnose hydronephrosis, renal tumours, abscesses and cysts including polycystic disease.
Assess and follow-up renal size and scarring in children with urinary tract infections.
Assess the bladder and prostate.
• The normal adult renal length, measured by ultrasound, is 9–12 cm.
• Renal length varies with age, being maximal in the young adult.• There may be a difference between the two kidneys, normally less than 1.5 cm.
• A kidney with a bifid collecting system is usually 1–2 cm larger than a kidney with a single pelvicaliceal system.
Causes of small kidney
Causes of large kidneys
Urography:
Indications:When detailed demonstration of the pelvicaliceal system and ureters are required
Suspected ureteric injury, e.g. following pelvic surgery or trauma
Assessment of acute ureteric colic
• Intravenous (Excretory) Urography
• Preliminary
• Immediate• Compression
• 5 minutes
• Release
• Post -micturation
• Check the Kidneys: outline, size, site
• Check the calyces: cupped• Check renal pelvis and ureter
• Check the bladder
Causes of calyceal dilatation:
A: Due to obstructionWithin the lumen:
• calculus
• blood clot
• sloughed papilla
• Within the wall of the collecting system
• intrinsic pelviureteric junction obstruction
• transitional cell tumour
• infective stricture (e.g. tuberculosis or schistosomiasis)
Extrinsic compression
• retroperitoneal fibrosis
• pelvic tumour, e.g. cervical, ovarian or rectal carcinoma
• aberrant renal artery or retrocaval ureter
B) Due to papillary atrophy or destruction:
• Reflux nephropathy
• Papillary necrosis
• Tuberculosis
Indication of CT urography
Investigation of renal calculi
Investigation of haematuria
Characterization of a renal mass
Staging and follow-up of renal carcinoma
To delineate renal vascular anatomy (e.g. suspected renal artery stenosis or prior to live related kidney donation)
To diagnose or exclude renal trauma
CT urography
MRIMRA
Radionuclide examination
Voiding cystourethrogram (micturating cystogram)Retrograde urethrogram
Urinary calculi
Nephrocalcinosis
Deposition of calcium salts in the medulla or cortex of the kidney.Medullary Nephrocalcinosis
Congenital intrinsic pelviureteric junction (PUJ) obstruction
In this disorder, peristalsis is not transmitted across the pelviureteric junction.Childern and young adult
Dilatation of the pelvis and calices, with an abrupt change in caliber at the pelviureteric junction
the ureter is either narrow or normal in size.
Renal parenchymal masses
In adults, the most common malignant tumour is renal cell carcinoma, whereas in young children the common neoplasm is Wilms’ tumour.Other masses: renal abscess, benign tumour (oncocytoma or angiomyolipoma), hydatid cyst, and metastasis.
Renal cysts
‘renal pseudotumour’ or column of Bertin
Multiple renal masses include:
• Multiple simple cysts• Polycystic disease
• Malignant lymphoma
• Metastases
• Inflammatory masses.
Renal cell carcinomas
Spherical and often lobulated, usually isodense to renal parenchyma.Focal necrotic areas may result in areas of low density, and stippled calcification may be present in the interior of the mass.
Renal cell carcinomas enhance, but not to the same degree as the normal renal parenchyma. The enhancement is inhomogeneous.
Check LN, liver, adrenal, pancreas, bone, renal vein and IVC
Acute infections of the upper urinary tracts
Most patients with acute urinary tract infection do not require urgent imaging investigations.In patients presenting with signs of infection associated with pain, particularly if the symptoms are not settling with antibiotics, ultrasound and plain films may diagnose underlying stones, obstruction or abscess formation
Investigation of the renal tract is indicated in all children with a confirmed urinary tract infection.
Urinary tuberculosis
Calcification is common. Usually, there are one or more foci of irregular calcification, but in advanced cases show (autonephrectomy). Calcification implies healing but does not mean that the disease is inactive.The earliest change on the post contrast films is irregularity of a calix. Later, a definite contrast-filled cavity may be seen adjacent to the calyx.
Strictures of any portion of the pelvicaliceal system or ureter may occur, producing dilatation of one or more calices. The multiplicity of strictures is an important diagnostic feature.
If the bladder is involved, the wall is irregular because of inflammatory edema; advanced disease causes fibrosis resulting in a thick-walled small volume bladder.
Multiple strictures may be seen in the urethra.
Chronic pyelonephritis (reflux nephropathy)
Local reduction in renal parenchymal width (scar formation). The upper and lower calices are the most susceptible to damage from reflux.Dilatation of the calices in the scarred areas
Overall reduction in renal size partly from loss of renal parenchyma.
Dilatation of the affected collecting system
Vesicoureteric reflux may be demonstrated at micturating (voiding) cystography.